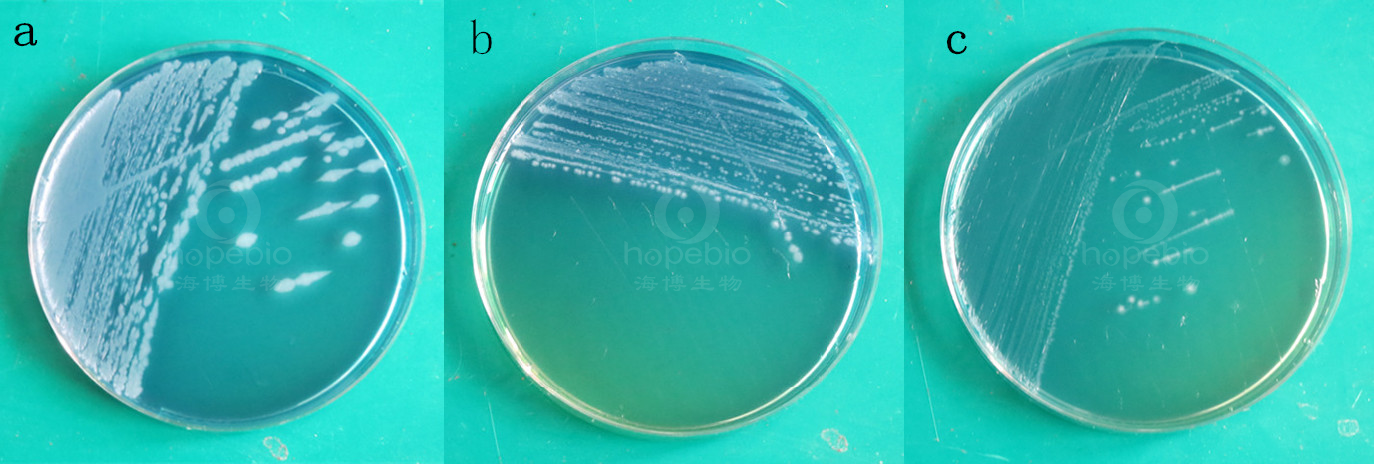

海博微信公众号
海博微信公众号
 海博天猫旗舰店
海博天猫旗舰店


 海博微信公众号
海博微信公众号
 海博天猫旗舰店
海博天猫旗舰店




一、试验原理
用于蜡样芽孢杆菌的酪蛋白分解试验。
酪蛋白分子量较大不溶于水,细菌可将酪蛋白分解为小分子的氨基酸,致使菌落周围形成透明圈。
二、培养基配方
|
酪蛋白 |
10.0 |
|
牛肉浸粉 |
3.0 |
|
氯化钠 |
5.0 |
|
磷酸氢二钾 |
2.0 |
|
琼脂 |
15.0 |
|
溴百里香酚兰 |
0.05 |
|
pH值 |
7.4±0.1 |
三、试验方法:
使用前,把制备好的平板放置室温10-20分钟。
1、制备质控菌液。
2、将质控菌液划线于平板上。
3、30±1℃倒置培养基培养24小时,记录实验结果。
四、结果观察与解释
接种以下质控菌株,30±1℃倒置培养基培养24小时:
|
质控菌株 |
菌株编号 |
接种量(CFU) |
生长情况 |
结果 |
|
大肠埃希氏菌 |
ATCC25922 |
>5000 |
+++ |
菌落周围没有透明圈,培养基由绿变蓝 |
|
蜡样芽孢杆菌 |
CMCC(B)63303\ |
>5000 |
+++ |
菌落周围有透明圈,培养基由绿变蓝 |
|
枯草芽孢杆菌 |
CMCC(B)63501 |
>5000 |
+++ |
菌落周围有透明圈,培养基由绿变蓝 |
图1-2 酪蛋白琼脂微生物质控结果
备注:a:蜡样芽孢杆菌b:枯草芽孢杆菌c:大肠埃希氏菌
五、注意事项
本培养基仅为细菌鉴定的一部分,需做其他补充试验。
相关产品:
注:本文属海博生物原创,未经允许不得转载。
上一篇:WS琼脂原理及实验现象
下一篇:赖氨酸脱羧酶肉汤的实验原理及方法



